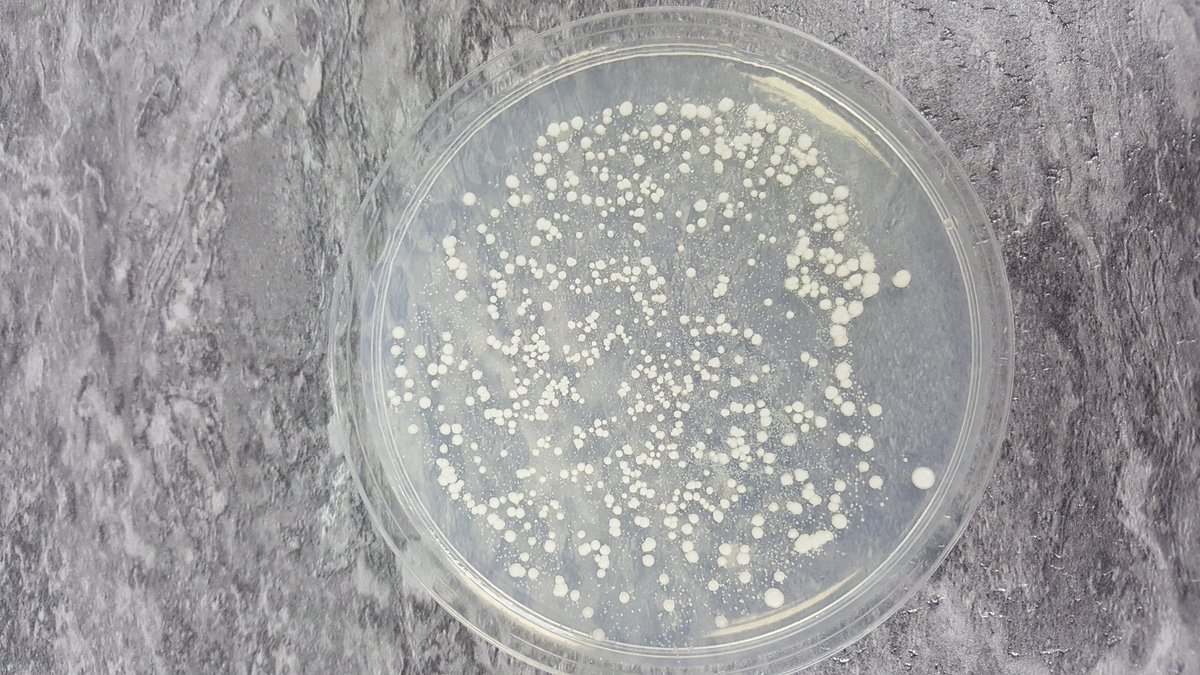
MPSMicro's tweet image. Never good to have spots.....

MPS Microbiological
@MPSMicro
Marilyn Seedhouse, Brewing Microbiologist, dedicated to keeping beer clean and beautiful.
You might like
Micro sampling and results will diagnose micro problems in the brewery. Overcoming the problems will require consistent and fastidious cleaning and disinfection protocols.
This yeast is very happy, very clean and well cared for. The brewer responsible for this yeast looks after it well. The beer this yeast helps to make is similarly clean and happy. Wonderful!

Please give casks and kegs an extra special clean after they have been out of use for so long. Lovely fresh beer deserves a clean, infection free home.
Tiny aliens can produce acid in your beer. Testing your process and improving hygiene where needed will make beer better.

Thought for the day...only produce a sour beer with intent, not by mistake!
If you have any microscopic aliens in your beer, bad things can happen!
I can help you to keep your beer clean and beautiful!
United States Trends
- 1. AJ Lee N/A
- 2. Becky N/A
- 3. Tozawa N/A
- 4. David Njoku N/A
- 5. Otis N/A
- 6. Alpha Academy N/A
- 7. Megyn Kelly N/A
- 8. Bediako N/A
- 9. The Usos N/A
- 10. Discord N/A
- 11. #RawOnNetflix N/A
- 12. Mikel Brown N/A
- 13. iTunes N/A
- 14. Stanley Cup N/A
- 15. Elimination Chamber N/A
- 16. Neal Shipley N/A
- 17. Sion James N/A
- 18. Fannin N/A
- 19. Maryse N/A
- 20. Fess Parker N/A
Something went wrong.
Something went wrong.